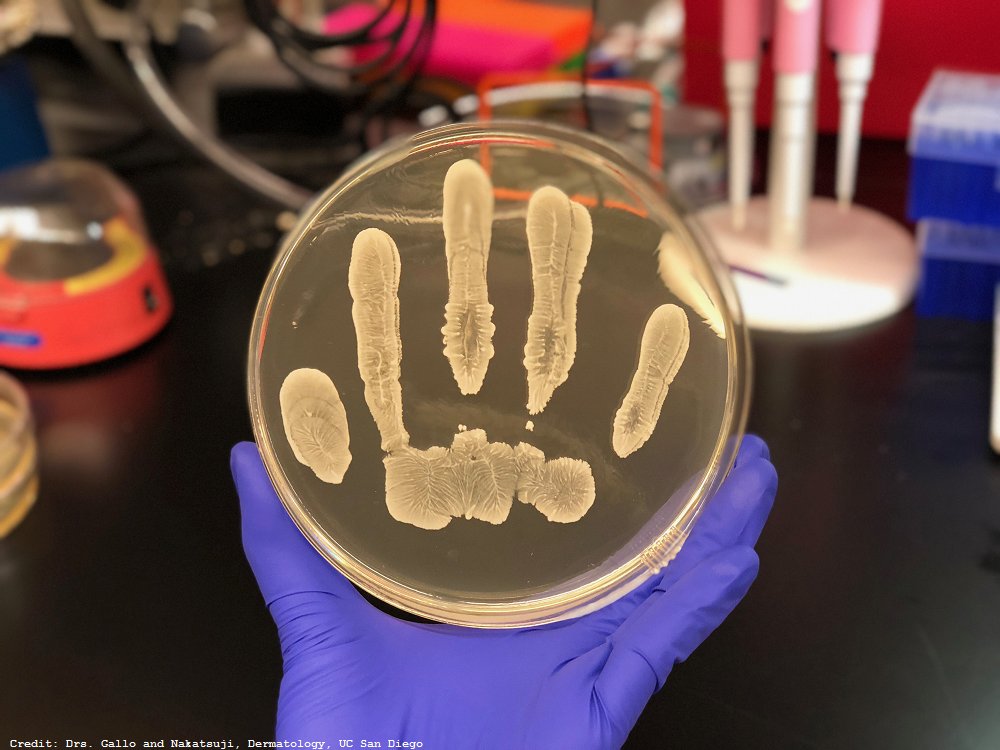
A strain of Staphylococcus found on our skin produces a compound that appears to halt the growth of tumors: scim.ag/2CP7vRT <a href="/ScienceAdvances/">Science Advances</a>

Pitt BGSA
@pittbgsa
University of Pittsburgh Biomedical Graduate Student Association. Student gov't representing School of Medicine graduate students.
FB: bit.ly/2kmv7Zw
ID: 703368653618737156
http://www.bgsa.pitt.edu 26-02-2016 23:58:49
110 Tweet
101 Followers
75 Following




Proud to receive the Pitt BGSA Distinguished Mentor Award - deep thanks to all the students, postdocs, fellows who have traveled through Lee-Oesterreich Lab #mentoring University of Pittsburgh UPMC MageeWomens Pitt BGSA Pitt Grad Studies #H2P leeoesterreich.org/bgsa-symposium…







Congrats to Nicole and Ashley in the lab and their MONSTER paper published today in Cell Reports studying how the TCR directly alters glycolytic flux, LDH activity, and consequent cytokine synthesis! #GMD cell.com/cell-reports/f…




A strain of Staphylococcus found on our skin produces a compound that appears to halt the growth of tumors: scim.ag/2CP7vRT Science Advances

Join WIB Pittsburgh for panel discussion on challenges women face in boardrooms & how we can promote for #inclusive #boardrooms womeninbio.org/events/EventDe… #PressforProgress #womeninscience #womenshistorymonth Pitt Innovates @2020WOB @PghLifeSciences Pitt Health Sciences














